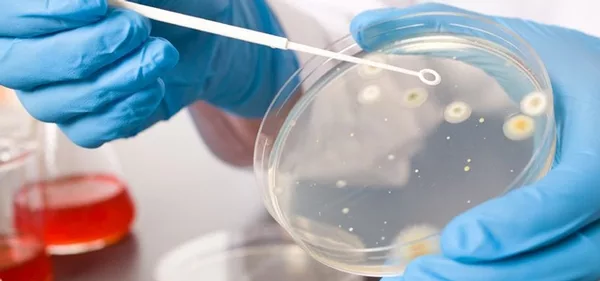

Key Goals of Emerging Technologies for Inactivating Bacteria
As interest in the development and use of novel thermal and non-thermal technologies to process foods increases worldwide, special attention must be paid to identifying the key goals for these new technologies. While a technology itself may prove successful in its operation, the more significant goal is that the technology is actually useful in the industry for which it is intended. For the food manufacturing industry, this means that the use of novel technologies ultimately must result in the production of nutritious, safe and high quality foods at a reasonable cost for the consumer.
The U.S. Food and Drug Administration (FDA) lately has become involved in analyzing emerging technologies for inactivating bacteria in foods to determine their viability with regard to regulatory approval for use and to establish whether there should be additional research before the introduction of these technologies into the food processing environment. This is the basis for the collaboration between FDA and the Institute of Food Technologists (IFT), from which a document was published in Journal of Food Science in December 2000, summarizing most of these emerging technologies, their benefits and limitations, and additional research needs.[1] FDA’s goal is to obtain an improved body of knowledge in order to develop policies that will affect the users of these technologies.
Novel technologies for the inactivation of bacteria in foods include both thermal and non-thermal approaches in system design. While we have established that most of these technologies have, in one way or another, thermal effects on the product, those considered “non-thermal” cause few of the changes to a product associated with thermal treatments. Tech-nologies based on thermal treatment of foods have been around for a long time, but there are a few that are considered emerging or novel, such as ohmic heating, radio frequency, microwave and induction heating. Although microwave is already used in the food industry, for example, it is not applied for pasteurization purposes, which makes it an established technology with an emerging application.
Among the available non-thermal technologies, irradiation, like microwave technology, is an established technology with an emerging application. This is because consumer perceptions must be overcome to make this proven technology more widely accepted. All three types of irradiation—X-ray, electron beam, and Cobalt-60—offer well-established benefits and limitations with regard to the inactivation of bacteria in food products. FDA, the World Health Organization (WHO), and many other government organizations and international bodies worldwide have approved the use of irradiation as a technological intervention to inactivate bacteria in foods. Several food companies are test marketing irradiated products, particularly ready-to-eat meats and ground beef, and recent surveys indicate that consumers are beginning to accept the use of this technological intervention.
In terms of promising emerging non-thermal technologies currently being evaluated or commerically applied there are several categories. First, the pulse-power technologies, which include light pulses, arc discharge, pulsed electric fields (PEF), oscillating magnetic fields, plasma and ozone, utilize energy supplied in pulses, which has a very interesting effect on microorganisms. Then, there are the “physical” nonthermal methods: ultrasound and high pressure processing (HPP). There also are chemical and biochemical methods, including antimicrobials and bacteriocins, that are gaining momentum as key bacterial interventions although many have been available for years.
As we evaluate these new technologies for use in the food industry, there are a number of issues to be considered, including safety, quality, consumer acceptance, efficacy, sensory aspect, microbial inactivation, and nutritional aspects. These aspects must be prioritized when developing the technologies, but ultimately, the first priority is microbial inactivation. Again, the technology may be very promising for many desired effects, but if it does not inactivate potentially harmful microorganisms, it will fail in the marketplace. In this article, we will review a few of the promising novel technologies with regard to this key goal and discuss their potential for commercialization and use in the food industry.
Novel Non-thermal Methods
In general, non-thermal methods offer many advantages to the food processor, including minimum changes in the quality of the food produced; minimum loss of flavors and nutrients; fresh-like taste; reduced energy utilization; and the facilitation of new food product development. It is important to note that many of these emerging nonthermal methods are being developed for use as part of a “hurdle” strategy, which involves the combination of more than one technology to take advantage of the resulting synergistic effects and optimize the process.
Pulsed Electric Field. This is an emerging nonthermal technology used for the preservation of fluid foods, such as fruit juices, beverages, liquid eggs, milk and sauces, which are pumped through a treatment chamber and subjected to high voltage impulses (Figure 1). Basically, a capacitor is charged to a switch, and the pulsed electric discharge takes place between two electrodes where the food is confined in the middle. Although primarily used in continuous systems, PEF also can be used in a batch process. The high electric field intensity developed in the fluid food is used to inactivate spoilage and pathogenic bacteria, as well as enzymes, by causing ultrastructural damage to the cells. The intensity of the electric field, which is defined by the voltage applied between the electrodes, and the distance between the electrodes are the main two factors in the successful inactivation of microbes. The shorter the distance between the electrodes and the higher the voltage one is able to use, the more effective PEF treatment will be.
The PEF process is very fast. Each pulse is completed in two microseconds, so the user can recirculate product or use two containers or multiple chambers in parallel, which makes PEF a very versatile technology. Several pulses, from 10 to 100, can be applied during the process, and since the pulses take just microseconds to complete, the user can realize energy cost savings. At present, approximately 10,000 liters can be processed per hour. Current research is focusing on the different configurations of the pulse wave shpaes that will optimize delivery of energy to the system.
The kind of food treated by PEF is an important factor in its effective application. If the food is very conductive, it will present some problems, because of difficulties in achieving overall field strength necessary for microbial inactivation. As such, PEF is particularly effective in the treatment of high-acid food products. The temperature of the food also is an important factor. In general, if the temperature of the food is raised it helps to promote microbial inactivation.
The cell size and characteristics of the targeted microorganisms affect the effectiveness of the PEF treatment. Studies have shown that gram-negative microbes are more suseptible to ultrastructural damage by PEF, although because different bacterial strains have different susceptibilities, some gram-negative species are not as susceptible as others. Research has shown that PEF can inactivate Saccharomyces cerevisiae in apple juice, L. innocua in milk and P. fluorescens in liquid whole eggs (Figure 2).

The complexity of PEF resides in putting the whole system together, and as such, this technology is not readily available to purchase as a turn-key system. However, researchers are making strides in developing system configurations that will allow the adoption of this technology by the food industry. Other limitations of PEF that are being addressed by researchers include difficulty in inactivating bacterial spores using this process; difficulties in using the process on nonhomogeneous foods and highly viscous fluids; foods entrapping air bubbles, making the process less effective; high electric conductivity and limited flow rates; and the presence of some heating effects that may be deletrious to some products.
As noted, PEF has been most successfully used with fluid products, and thus the benefits of its use have centered on evaluations associated with these types of products. Juices, which are high acid liquids, are easily treated with this method; shelf life of milk is extended by PEF because the process inactivates certain enzymes; and nonthermal pasteurization of liquid egg results in a higher quality product because it has not been subjected to temperatures that harm its functionality. And the combination of PEF with some other non-thermal methods, such as the addition of natural antimicrobials like nicin and lysozyme, is proving to increase the effectiveness of microbial inactivation.
Arc Discharge Processing. This non-thermal technology used to pasteurize liquid foods is based on the application of rapid discharge voltage through an electrode gap below the surface of aqueous suspensions. In arc discharge, a multitude of physical effects and chemical compounds are generated that can inactivate microorganisms present in liquid food media. Enzyme inactivation by arc discharge is attributed to oxidation reactions mediated by free radicals and atomic oxygen.
Recent experiments demonstrate that arc technology could be an alternative to heat pasteurization of juices and process water. Arc discharge can obtain 6- to 7-log reductions of pathogenic bacteria inoculated in orange juice, without affecting the taste or color of the product. Arc discharge can reduce total microbial plate counts in fresh squeezed grapefruit juice by more than 50%, boosting refrigeration shelf life and fresh flavor to more than 100 days. Again, because it is a pulse-power technology, it should be very energy-efficient. However, thus far this technology has been used only in food pasteurization experiments and has not been commercially developed.
Light Pulses and Ultraviolet Light. Light pulse technology is an extension of ultraviolet light technology using a wider spectrum. This non-thermal method is promising on paper and has found good application in the pharmaceutical industry, although not many applications in the food industry. Since foods are not perfectly shaped, the uniformity of the treatment typically is compromised. The closest food-related application is its use as a method to purify water.
Ultraviolet light treatments are approved by FDA for use as a treatment for clear juices and liquids. A separate discussion of UV appears in this article. (See “Ultrasonics and Ultraviolet: Non-thermal Tech Heats Up” )
High Hydrostatic Pressure (HHP). Also known as high pressure processing (HPP), this technology currently is being applied by several food companies throughout the world. High pressure kills microorganisms by interrupting their cellular function without the use of heat that can damage taste, texture and nutrition of some foods. An automated high pressure processing system involves placing a flexible packaged product into a handling basket that is placed into a vessel in which ultra-high hydrostatic pressure (UHP) of up to 100,000 psi is uniformly applied to both pre- and post-packaged foods, typically from 30 seconds to a few minutes, to achieve nonthermal inactivation of bacteria.
HPP acts instantaneously and uniformly throughout a mass of food independent of size, shape and food composition. Compression of foods may shift the pH of the food as a function of imposed pressure and must be determined for each food treatment process. Water activity and pH are critical process factors in the inactivation of microbes by HPP. Current pressure processes include batch and semi-continuous systems.
The application of HHP technology in food processing offers many benefits. First and foremost, the prevention of microbial contamination in food products varying from fish, meat, ham, eggs and rice, to starches, soy bean protein, cheese, pickles, desserts, seasonings and spices. Table 1 shows the results of a study using two types of juice samples treated by HPP. E. coli O157:H7 is inactivated two months after treatment, so the food safety promise of this technology is fulfilled. It also allows for the manufacture of partially cooked foods, like fish, meat and eggs. In addition, studies have shown that HPP prolongs the shelf life of many foods, including milk, fruit juices, desserts, pickles, cheese, seasonings and spices. HPP also appears to aid in the development of new foodstuffs from fish, meat, eggs, rice, starches and soy bean protein. Additional quality and functionality improvements to foods and beverages include increases in the digestibility of meat proteins, faster thawing of frozen foods and the modification of foaming, emulsifying, gelling and water binding capacity of proteins.

Some of the current limitations on the use of HHP to process foods include equipment cost and throughput; limited to batch operation in most cases; applicable only for high added-value products; maintenance and operational costs; and it does not offer a new product development aspect.
High hydrostatic pressure is an “emerged” technology, because commercialization of such systems is ongoing. Several companies are already using or developing UHP technology, including Minute Maid, Atlanta, GA (juices), Avomex, Fort Worth, TX (guacamole), Motivatit Seafood, Houma, LA (to kill Vibrio vulnificus in raw oyster processing), and Hormel Corp. (USA) and Espuña (Spain) for sliced ham. Further applications include meat, cold cuts and wine, and the acidity of fruit juices makes them ideal for high-pressure treatment. It is a very promising technology for the processing of many kinds of fruits and vegetables. For example, Avomex has used HHP for treating the avacado puree used in its guacamole products to great effect. The guacamole has been sold in supermarkets in the southern U.S. for nearly two years. It has a “fresher” taste than any of its conventionally processed competitors, and its market share continues to grow. Avomex has since introduced other quality pressure-processed products, including several varieties of salsa. The company also is considering using high pressure for processing carrot juice, apple juice, garlic puree, mango, guava and other subtropical fruit and vegetables.
Novel Thermal Methods
Microwave and radio frequency processing. Microwave and radio frequency heating refers to use of electromagnetic waves of certain frequencies to generate heat in a material. Microwave and radio frequency heating for pasteurization and sterilization are preferred to conventional heating because they require less time to rise to the desired process temperature, particularly for solid and semi-solid foods. Although industrial microwave pasteurization and sterilization systems have been reported on and off for three decades, commercial radio frequency heating systems for the purpose of food pasteurization or sterilization are not known to be in use.
The critical factors affecting the effectiveness of microwave heating are the size, shape, composition (moisture, salt, and so on); multiple components (as in a frozen dinner), and liquidity/solidity of the food being treated; the presence of metallic elements in the packaging, such as aluminum foil or susceptor; the power level used, cycling, presence of hot water or air around the food and equilibration time used in the process; and even the dimensions, shape and other electromagnetic characteristics of the oven itself, including the method of agitation of the food and the presence of mode stirrers and turntables. Time also is a factor in the sense that, as the food heats up, its microwave absorption properties can change significantly and the location of cold points can shift.
Thus far, the lack of success of microwave technology in commercial operation is attributed to the complexity of the method; expense; non-uniformity of heating; inability to ensure sterilization of the entire package; lack of suitable packaging materials; and unfavorable economics when compared to prepared frozen foods in the U.S.
Ohmic Heating. Ohmic heating is defined as a process wherein electric currents are passed through foods or other materials with the primary purpose of heating them. Ohmic heating is distinguished from other electrical heating methods either by the presence of electrodes contacting the food (as opposed to microwave and inductive heating, where electrodes are absent); frequency (unrestricted, except for the specially assigned radio or microwave frequency range); and waveform (also unrestricted, although typically sinusoidal).
A large number of potential future applications exist for ohmic heating, including use in blanching, evaporation, dehydration, fermentation and extraction. The principal advantage claimed for ohmic heating is its ability to heat materials rapidly and uniformly, including products containing particulates. The principal mechanisms of microbial inactivation in ohmic heating are thermal. While some evidence exists for nonthermal effects of ohmic heating, for most ohmic processes, which rely on heat, it may be unnecessary for processors to claim this effect in their process filings.
Food Safety is Priority One
Food safety should be always the main concern in the validation of any emerging food technology. Efforts like the collaboration of FDA-IFT should be imitated in order to clarify the possibility of each new technology. There is a real potential for the commercial implementation of non-thermal technologies. A combination of sound technologies should be explored with much more intensity, since this approach increases the effectiveness of microbial inactivation to a greater degree in many instances.
The expectations for emerging and non-thermal technologies are sustained by positive and challenging results obtained by many research organizations worldwide. While many questions about these technologies remain, the food industry is showing an increasing interest in investing in the answers that will further approve food safety and quality assurance aims for their consumers.
Gustavo V. Barbosa-Canovas, Ph.D., is Professor of Food Engin-eering at Washington State University, Pullman, WA, where he operates one of the largest research facilities dedicated to the study, development and evaluation of emerging and novel thermal and nonthermal processing technologies for the food industry. He is actively involved in the Non-Thermal Technologies Division of IFT. He is coauthor of Pulsed Electric Field in Food Processing. Contact him at barbosa@mail.wsu.edu.
Reference
1. U.S. FDA, Center for Food Safety and Applied Nutrition. Report on Kinetics of Microbial Inactivation for Alternative Food Processing Technologies. www.cfsan.fda.gov/~comm/ift-toc.html. June 2001.
Ultrasonics and Ultraviolet: Non-thermal Tech Heats Up
To help the food industry to meet consumer requirements, food researchers have pursued the discovery and development of improved preservation processes with minimal impact on the fresh taste, texture and nutritional value of food products. Both improved heating technologies and non-thermal processing technologies have been investigated for their effect on food freshness, nutrition, and safety. Over the past few years, several technologies have been the object of rapid developments in equipment design and scientific understanding, which has helped to eliminate many of the barriers to their commercial application (Table 2).

In addition to high pressure processing and pulse electric field, two of the most innovative of the nonthermal technologies are ultrasonics and ultraviolet light (UV).
Ultrasonics
Ultrasonics is energy generated by sound waves of 20,000 or more vibrations per second (kHz). Ultrasound technology has a wide range of current and future applications in the food industry, including some microbial inactivation applications. High power ultrasonics has a bactericidal effect, caused by intracellular cavitation, the micro-mechanical shocks that disrupt cellular structure and function. Because foods contain particulates and other substances that interfere with sound wave penetration, however, ultrasonics is usually applied in combination with other preservation methods. Ultrasonics appears to have the greatest potential for food product safety applications when combined with other processes, such as mild heat or antimicrobials during washing.
Applications. Ultrasonics has a number of food safety applications unrelated to destruction of microorganisms in food, which can be quite cost-effective. For example, power ultrasonics can be used as a processing aid, speeding up mass and heat transfer unit operations, which can result in improved efficiencies in several applications. It can be used to improve the cleaning of process equipment; the strategic mounting of transducers can provide mechanical disturbance in areas that are difficult to clean. The efficacy of fresh food washing can be improved by the application of ultrasonics, reducing or eliminating the need for chemical washes. In surface coating applications, ultrasonics can be used to improve the adhesion of the coating. Ultrasonics has been found to improve heat transfer in the surface heating and cooling of liquids.
When ultrasonics is applied to freezing liquids, very fine crystals may be generated by maximizing ice crystal formation with a limited degree of super cooling. Faster freezing rates are possible, as are finer and more uniform crystal size, reducing food product damage and improving the texture of ice creams and the quality of thawed frozen products.
When ultrasonics are applied to solid media, they can induce molecular excitation, leading to changes in crystal structures. High local temperatures can be induced, which is used for fusion welding of some materials. At higher levels, they can cut material without the need for direct surface contact. The recent development of ultrasonic knives is of great potential value to the food industry for difficult-to-cut materials such as crumbly cheeses.
Many other new areas of potential application of power ultrasonics are currently being investigated for the food industry, including emulsification, homogenization, extraction, defoaming, enhanced enzyme kinetics, enhanced drying and enhanced filtration.
Limitations. Ultrasonics usually must be combined with other processes, increasing the need to understand optimum process interaction. Many products are unsuitable for ultrasonics applications, with the result that no commercial products have as yet been released. This is due in part to the fact that some materials are opaque to ultrasound, so the ultrasonic energy is absorbed strongly, reducing its effect on the rest of the system. Sonic resonances in the audible frequency range and high sound pressure levels at ultrasonic frequencies also are potential sources of occupational safety problems.
Ultraviolet Light
Ultraviolet processing uses radiation from the ultraviolet region of the electromagnetic spectrum. The antimicrobial properties of UV irradiation are believed to be due to damage to the DNA, reducing the ability of the microbial population to reproduce in a food product exposed to UV.
Applications. Ultraviolet light has been used for the decontamination of air in food factories, for the surface treatment of bakery products and for the treatment of drinking water, water for food and beverage formulation, wash water and waste water. UV liquid treatment systems appear to be suitable for clear and translucent liquid foods, including fruit and vegetable juices (apple, pear, berry, carrot, celery, spinach, kiwi fruit), particularly as some of these change in flavor and color when thermally treated.
Advantages and Limitations. Ultraviolet systems can provide relatively low-cost decontamination and shelf life extension of fresh juices and other liquid streams, as has been the case for recently approved apple juice products by the U.S. Department of Agriculture (USDA), but the microbiological safety needs to be monitored carefully. As with traditional and other new technologies, when liquids are treated in continuous flow they need to be packaged aseptically in pre-sterilized packages to prevent recontamination after treatment.
Randall Pearce, Judy Marcure and Cornelis (Kees) Versteeg, Ph.D., Food Science Australia (FSA): A Joint Venture of CSIRO and Afisc. (Excerpts reprinted from “Opportunities for Industrial and Scientific Collaboration in Asia-Pacific Countries,” Asia Pacific Tech Monitor, Asian and Pacific Centre for the Transfer of Technology, New Delhi, India, May/June 2002, pp. 16-22; postmaster@apctt.org).
FSA (Sydney, Melbourne and Brisbane, Australia) operates the Innovative Foods Centre (IFC), which aims to advance knowledge about innovative technologies and facilitate their adoption by the food industry for the development of safe and innovative food products. The food-related research divisions of FSA and TNO Food Science and Nutrition (Zeist, The Netherlands)—two of the world’s largest and most prestigious R&D groups—are collaborating to offer industry access to a unique range of non-thermal processing technologies and related analytical, applications and product development research.
For more information about the combined research capabilities and achievements of CSIRO and TNO Food Science and Nutrition, please contact U.S. FSA representative Larry Keener, International Product Safety Consultants at (206) 283-2897; Lkeener@aol.com.
Looking for quick answers on food safety topics?
Try Ask FSM, our new smart AI search tool.
Ask FSM →








